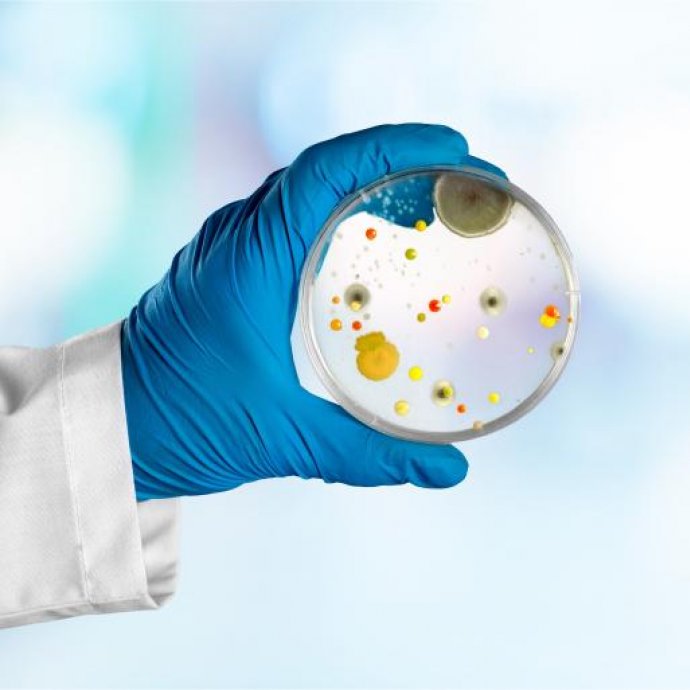
REGULAMENTO DE EXECUÇÃO (UE) 2024/2959 DA COMISSÃO que designa laboratórios de referência da União Europeia para a saúde pública - Água e Alimentos REGULAMENTO DE EXECUÇÃO (UE) 2024/2959 DA COMISSÃO que designa laboratórios de referência da União Europeia para a saúde pública - Água e Alimentos

2024-12-02
REGULAMENTO DE EXECUÇÃO (UE) 2024/2959 DA COMISSÃO que designa laboratórios de referência da União Europeia para a saúde pública - Água e Alimentos
Saiu hoje no JOUE o REGULAMENTO DE EXECUÇÃO (UE) 2024/2959 DA COMISSÃO que designa laboratórios de referência da União Europeia para a saúde pública no domínio das bactérias transmitidas por alimentos e pela água, no domínio dos helmintos e protozoários transmitidos por alimentos, pela água e por vetores, e no domínio dos vírus transmitidos por alimentos e pela água.
Considerando o seguinte:
- Nos termos do Regulamento (UE) 2022/2371, os laboratórios de referência da União Europeia («laboratórios de referência da UE») no domínio da saúde pública e em domínios específicos da saúde pública relevantes para a aplicação desse regulamento devem prestar apoio aos laboratórios nacionais de referência e promover boas práticas e o alinhamento dos Estados-Membros em matéria de diagnóstico, métodos de ensaio e utilização de determinados testes para a vigilância, notificação e comunicação uniformes de doenças pelos Estados-Membros.
Artigo 1.º
1. O consórcio referido no anexo I é designado como o laboratório de referência da União Europeia para a saúde pública no domínio das bactérias transmitidas por alimentos e pela água até 22 de dezembro de 2031.
2. As responsabilidades e tarefas desse laboratório de referência da União Europeia estão estabelecidas no referido anexo.
Artigo 4.º
O presente regulamento entra em vigor no dia seguinte ao da sua publicação no Jornal Oficial da União Europeia.





